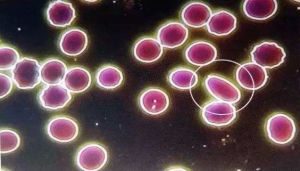
紅細胞顆粒 紅細胞顆粒

解釋
紅細胞顆粒erythrocyticgranule
真紅細胞顆粒增多是什麼病
真性紅細胞增多症是一種克隆性幹細胞疾病,以全血容量增多,血粘度增高及脾腫大為主要表現。多見於老年人。
一、病史及症狀
⑴病史提問:注意起病緩急,是否有血栓形成及出血病史,是否伴有神經系統症狀。是否有長期高原居住史。有無心肺疾病及腫瘤病史。
⑵臨床症狀:頭昏、頭疼、耳鳴、乏力、健忘、皮膚瘙癢及肢體麻木,可有復視、視力模糊、多汗、足痛及體重減輕。如有血栓形成可出現相應症狀。
二、體檢發現
面部、手、足、結膜充血或輕度紫紺,呈醉酒狀;30%病人有血壓升高及肝臟腫大;75%以上有脾腫大;偶有骨骼壓痛。皮膚黏膜可見瘀點或瘀斑。
三、輔助檢查
血象:血紅蛋白≥180g/L(男),≥170g/L(女);紅細胞計數≥6.5×1012/L(男),≥6.0×1012/L(女)。白細胞計數>12.0×109/L(無發熱及感染)。血小板計數>400×109/L。
骨髓象:增生明顯活躍,粒、紅及巨核細胞系均增生,以紅系增生顯著。
紅細胞容量增加:51Cr標記紅細胞法:男>39ml/kg,女>27ml/kg。
紅細胞壓積增高:男性≥55%,女性≥50%。
中性粒細胞鹼性磷酸酶積分增高>100(無發熱及感染)。
動脈血氧飽和度正常(≥92%)。血清維生素B12增高(>666pmol/L)
四、鑑別診斷
應與高原性紅細胞增多症、嚴重心肺疾病、異常血紅蛋白病;某些腫瘤(腎上腺樣瘤、肝癌、腎癌等)、囊腫和血管異常引起的繼發性紅細胞增多症鑑別。